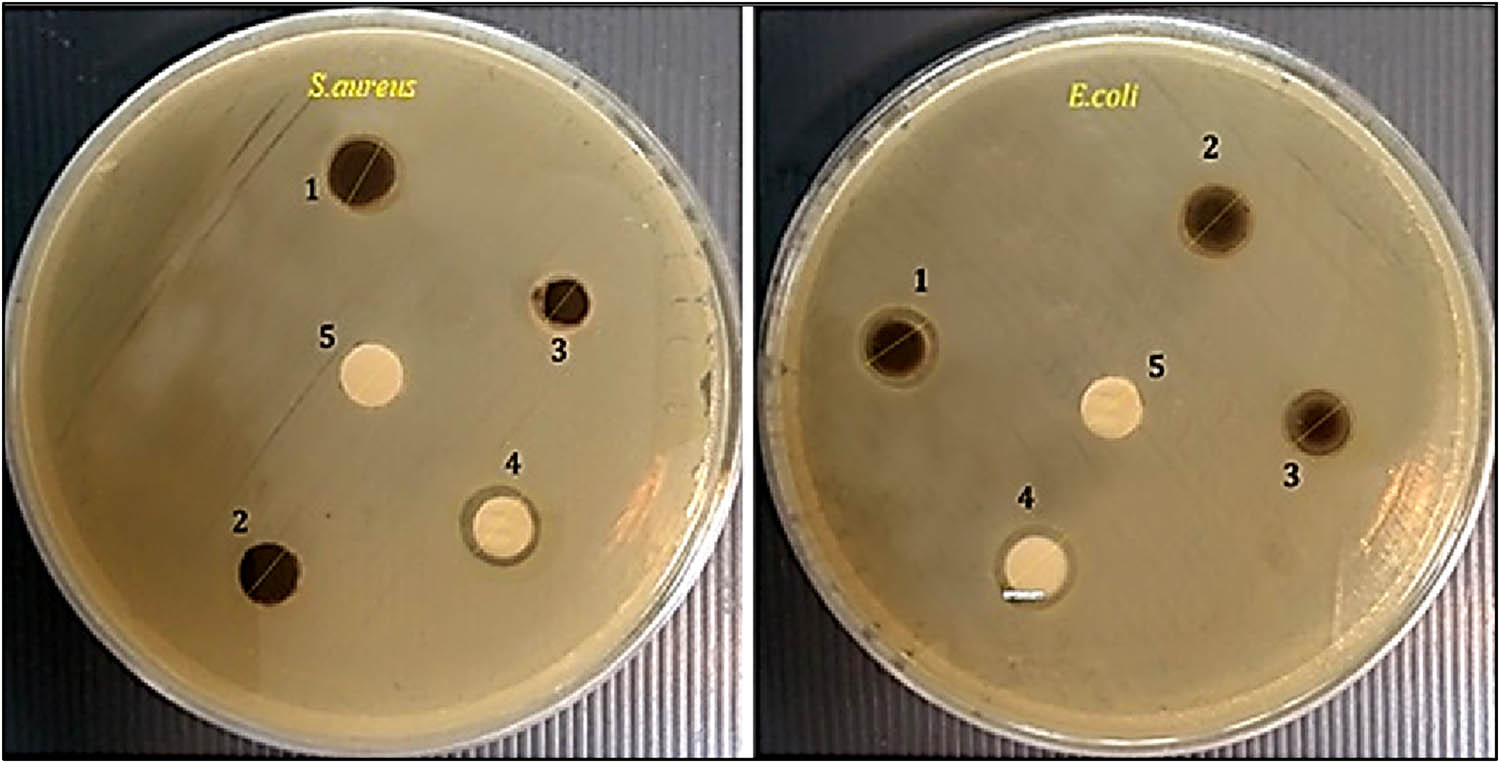
Figure 9 
                  Disc diffusion assay exhibiting the impact of green-synthesized NPs as antibacterial agents against S. aureus and E. coli. (1) Green synthesized (N. sativa-iron oxide) NPs, (2) IONPs, (3) N. sativa extract, (4) erythromycin (C +ve), and (5) DW (C −ve).

Green synthesis, characterization, cytotoxicity, and antimicrobial activity of iron oxide nanoparticles using Nigella sativa seed extract
-
Hassan Al-Karagoly
, Atiaf Rhyaf
, Hala Naji , Salim Albukhaty , Faizah A. AlMalki , Amal A. Alyamani , Jawaher Albaqami and Salman Aloufi
Abstract
Green synthesis of nanoparticles (NPs) is a more sustainable, safe, and environmentally friendly method. This study aimed to investigate the synthesis procedure of iron oxide nanoparticles (IONPs) using the seed extract of Nigella sativa (N. sativa) as a strong reducing agent and to estimate their cytotoxic and antibacterial properties. The obtained IONPs were characterized by field-emission scanning electron microscopy, X-ray diffraction, dynamic light scattering (DLS), zeta potential (ZP), and Fourier-transform infrared spectroscopy analyses. The cytotoxicity of the biosynthesized IONPs was demonstrated by the MTT on a Vero cell line. Furthermore, the antibacterial activity of the fabricated biosynthesis metal oxide NPs was tested on Escherichia coli (E. coli) (ATCC 35218) and Staphylococcus aureus (S. aureus) (ATCC 29213) bacterial strains using the Kirby–Bauer disk diffusion method. This study showed the formation of a well-dispersed, highly stable (ZP ζ = −51.8 mV) IO NPs with an average diameter of about 31.45 nm. Moreover, the biosynthetic NPs (IONPs) exhibited a significantly noncytotoxic effect when analyzed by the MTT assay. The biosynthetic NPs (NS-IONPs) exhibited excellent antibacterial activity against E. coli and S. aureus, where the inhibition zones were 12.34 ± 0.58 and 11.52 ± 0.58, respectively.
1 Introduction
Magnetic iron oxide nanoparticles (IONPs) are one of the most commonly used inorganic nanoparticles (NPs) in various industries, including chemical, medicinal, pharmaceutical, electronic, and agricultural industries, due to their unique properties such as high saturation magnetization, which allows for easy magnetic separation in the presence of an external magnetic field [1,2]. IONPs can be synthesized using various methods, such as sol–gel, chemical reduction, co-precipitation [3], hydrothermal synthesis, and pulsed laser ablation in dimethylformamide (DMF) [3,4,5,6]; however, the chemicals used in these processes are considered hazardous to the environment [7]. Green NP synthesis using bioresources has sparked considerable interest as a promising method not only for reducing the toxicity of NPs that is often linked with traditional chemical synthesis methods but for its low cost, convenience of use, and environmentally friendly nature [8].
Plant extracts are used as a reducing and capping agent in the biosynthesis of NPs, decreasing the need for toxic-reducing chemicals [9]. Recently, numerous investigations have been performed on the environmentally friendly production of iron-based NPs using diverse plant parts such as Cynometra ramiflora fruit extract, Persea americana rind and Punica granatum seed extract, and Avicennia marina flower extract; Nigella sativa; Glycyrrhiza glabra; Cynodon dactylon; and fungi such as Aspergillus flavus and Phoma exigua [10,11,12,13,14,15]. Various reducing agents such as DMF, hydrazine carbon monoxide (CO), sodium borohydride (NaBH4), and others have been utilized in the synthesis of IONPs. These reducing agents are highly reactive compounds that negatively affect the environment and impair IONP biocompatibility, resulting in restricted biomedical applications of IONPs [16,17].
So, IONPs must be entirely biocompatible for biomedical applications [18]. As a result, biogenic reduction/green synthesis methods that are novel and environmentally friendly are in high demand [19].
Biogenic reduction techniques, which involve bacteria, fungi, algae, and higher plant extracts, are among the best options for producing metal and metal oxide NPs [20]. These more environmentally friendly methods are cost-effective, produce a good yield, and are fairly reproducible [21].
There are a couple of successful studies in synthesizing IONPs by using plant extracts, for instance, fruit extract of Ficus carica (common fig) [22], leaf extract of F. carica [23] and Carica papaya [24], and also seed extract of fenugreek seed [25]. However, there are only finite studies on the synthesis of IONPs from the seed extract of N. sativa.
N. sativa is a plant belonging to the Ranunculaceae family. It is a traditional medicinal plant that grows in various locations worldwide, particularly in Iraq and Saudi Arabia [26]. N. sativa has a rich source of nutritionally important elements, and its oil contains polyunsaturated fatty acids and other phytochemicals with high antioxidant activities and a glucose-lowering impact [27].
In this study, we used N. sativa as a reducing agent in the green synthesis technique to synthesize IONPs, combining the therapeutic properties of N. sativa’s seed extract with the critical properties of IONPs and evaluating their antibacterial effectiveness against E. coli and S. aureus.
2 Materials and methods
2.1 Chemicals and plant collection
All chemicals used in this study, including tetrahydrates of iron–iron oxide (FeCl2·4H2O, 99%), hexagonal-ferrous chloride (FeCl3·6H2O, 99%), ammonia (NH3, 25%), tetramethylammonium hydroxide (25%), NaOH (99.99%), absolute ethanol (≥99.8%) (GC), and nutritional broth, were obtained from Sigma-Aldrich Pty Ltd (Darmstadt, Germany) and used without further purification. In June 2021, N. sativa seeds were obtained from the faculty of the University of Al-Qadisiyah, Al-Diwaniyah, Iraq. The seeds were collected and stored at 4°C until further study.
2.2 Bacterial strains
The tested bacteria were Gram-positive and Gram-negative, including Staphylococcus aureus (ATCC 29213) and Escherichia coli (ATCC 35218).
2.3 Synthesis of IONPs
2.3.1 Preparation of the plant extract
Following the Jalali and Tehranipour [28] method, with some modifications, about 100 g of N. sativa seeds were mixed with 70% ethanol in a Soxhlet extractor in the central laboratory of the College of Veterinary Medicine, University of Al-Qadisiyah. Under low pressure, 32% of the obtained extract was concentrated and stored at 4°C until required.
2.3.2 Gas chromatography-mass spectrometry (GC-MS) analysis
The seed extract of N. sativa was analyzed using GC-MS (Shimadzu GC 17A, Japan). For the analysis, 1 μL of the extract was injected at a 20:1 split ratio. Helium gas (99.9%) was used at 1 μL per minute in the gaseous form. The experiment was carried out in the electron impact (EI) mode with a 70 eV ionization energy. The temperature of the injector was held constant at 250°C. The temperature of the column oven was set at 50°C (held for 3 min), increased to 280°C (held for 3 min) at 10°C per min, and finally at 300°C held for held for 10 min. After comparing the spectral configurations acquired with the available mass spectral databases (NIST and WILEY libraries [multiplier voltage of 1 kV]), the compounds were characterized [29,30,31].
2.3.3 Preparation of green-synthesized (N. sativa-iron oxide) NPs
The biosynthesis of IONPs was carried out using a method described earlier by Bibi et al. [32]. To prepare IONPs, distilled deionized water was used as the solvent. In all, 4.0 mL of FeCl3 (1 M) and 1.0 mL of FeCl2 (2 M) were mixed in a 100 mL container under vigorous shaking. The co-precipitation method, the most common method, was used for preparing magnetic IONPs for biomedical applications [33]; an aqueous solution of NH3 (50 mL and 1.0 M) over 5 min was slowly added to this mixture. The residue was then treated with 25% tetramethylammonium hydroxide and the reaction mixture was gently stirred for 2–3 min. The powder was accurately weighed, transferred to a flask, and dissolved in ultrapure water by ultra-sonification for 5 min using the dispersion method.
2.3.4 Characterization of green-synthesized IONPs
2.3.4.1 Field-emission scanning electron microscope (FESEM)
The morphological features and size of green-synthesized IONPs were studied using an FESEM (MIRA3 TESCAN-XMU, Brno, Czech Republic) at a 20 kV electron acceleration.
2.3.4.2 X-ray diffraction (XRD) test
Applications of Cu–Kα-wavelength (T = 1.5405 Å) were produced using a Phillips diffractometer in samples of green-synthesized IONPs. The voltage used was 40 kV, and the current intensity was 25 mA.
2.3.4.3 DLS measurement
DLS measurements of the prepared green-synthesized IONPs were carried out using Horiba SZ-100 nanoparticle analyzer. An appropriate powder concentration of 0.01 g per 100 mL is distributed in DMSO. The same medium has been used to estimate the cytotoxicity effect on the distribution of DMSO particles.
2.3.4.4 Determination of zeta potential (ZP)
ZP measurements were performed using Horiba SZ-100 nanoparticle analyzer to investigate particles’ surface charge of prepared green-synthesized IONPs. The particle’s electrostatic potential was calculated in ultrasonic dispersion of 0.01 g per 100 mL in DMSO at room temperature.
2.3.4.5 FTIR analysis
To study the chemical bonds formed between the N. sativa (NS) seed extract and IONPs, IR spectra analysis of the NS-IONP layers was performed. The spectra were acquired in the 400–3,500 cm−1 wavenumber range in an attenuated total reflection (ATR) mode using an FTIR instrument (Shimadzu Corporation, Japan) with 4 cm−1 resolution. The spectra have been acquired in transmittance mode by placing the samples on the diamond–ZnSe crystal plate of the ATR unit inserted into the spectrometer and analyzed using Version 1 25 Sp5, supplied by Shimadzu. The spectrum of the NS-IONP layer was recorded after 32 scans.
2.3.4.6 MTT assay
To measure the cytotoxic effect and biocompatibility of prepared green-synthesized IONPs, the MTT assay was used by following the instructions from the manufacturer. At a density of 1 × 105 cells per well, Vero cultures were incubated at 37°C in the presence of 5% CO2. Green-synthesized IONPs were added in five concentrations 12.5, 25, 50, 100, and 200 μg·mL−1 for 48 h, followed by washing twice before introducing 100 µL of cultivated medium and 0.5 mg·mL−1 of MTT reagent each to a fresh source. Green-synthesized IONPs were washed twice with phosphate-buffered saline (PBS). The unlabeled cells were used as the control group, while Triton-X was used as the positive control. Later, the labeled cells were incubated at 37°C in 5% CO2 for 4 h. The medium was tactfully aspired and replaced by 100 µL of fresh DMSO. The absorbance of the dissolved formazan product was examined at a wavelength of 570 nm.
2.3.4.7 Antibacterial activity
Kirby–Bauer disk diffusion method was used to test the antibacterial activity, which was considered a suitable method for evaluating the antibacterial activity of a newly synthesized material [34]. Briefly, four or five bacterial colonies were collected using a sterile inoculating loop and suspended in 2 mL of sterilized PBS; the studied bacteria include S. aureus (ATCC 29213) and E. coli (ATCC35218). The turbidity of bacterial suspension has been modified to a 0.5 McFarland level by diluting it with sterile PBS. Swabs that are free from bacteria were put into the inoculum channels. Bacteria were streaked onto Muller–Hinton agar plates by using swabs. Green-synthesized IONP suspensions were prepared by dissolving 0.1 mg of green-synthesized IONPs in 1 mL of distilled water. Sonication was carried out on the suspension for 10 min before usage. In all, 35 μL of green-synthesized IONP suspensions and distilled water (as a negative control) were used to impregnate the standard antibiotic disc (as a positive control). The final step was to conduct a disc diffusion assay on Mueller–Hinton agar plates against two different bacterial strains (Merck, Germany). Sterile forceps were used to put disks impregnated with culture medium on the surface of the agar. The bacterial activity was evaluated using plates incubated at 37°C for 24 h. The zone of inhibition (this activity) was measured in millimeters. The assays were repeated three times.
2.3.4.8 Statistical analysis
The mean ± standard deviation (SD) was used to analyze our results. For assessing statistical significance, Excel was also used. A p-value less than 0.05 or 0.01 was considered statistically significant. All required statistical analyses were performed using the statistical program SPSS version 19.0 (SPSS Inc., Chicago, IL, USA).
3 Results and discussion
3.1 Gas chromatography-mass spectrometry analysis
The ethanolic extract of N. sativa seeds was subjected to gas chromatography–mass spectrometry analysis, revealing various peaks. The database of the spectrum of known components from the GC-MS library was used to interpret the chromatogram peaks. The extract contained 15 main elements, according to GC-MS profiling. The peak regions for several chemicals are shown in Table 1, and Figure 1 lists the discovered compounds and their peak area (%) and retention duration (RT).
GC-MS analysis of N. sativa seed extract
| No. | Compound name | RT | Peak area (%) |
|---|---|---|---|
| 1 | Butyric acid-2-D1 | 8.939 | 3.18 |
| 2 | R-5,6-o-benzylidene-d-galatose | 13.309 | 0.25 |
| 3 | 4-Methanoazulene | 14.904 | 0.08 |
| 4 | 2-Ethyl-1-(isopropylamino)-1-cyanobutene | 18.165 | 0.64 |
| 5 | Tetradecanoic acid, ethyl ester | 20.682 | 0.41 |
| 6 | 9-Octadecenoic acid (Z) | 23.072 | 0.47 |
| 7 | Hexadecanoic acid, ethyl ester | 23.345 | 13.56 |
| 8 | d-Arabino-hexose | 24.287 | 0.10 |
| 9 | Nonanoic acid, 9-oxo-, ethyl ester | 24.576 | 0.10 |
| 10 | Butyl 4-(2,4-dichlorophenoxy)butyrate | 24.701 | 0.14 |
| 11 | Linoleic acid ethyl ester(ethyl linoleate) | 25.439 | 75.28 |
| 12 | Octadecanoic acid, ethyl ester | 25.762 | 2.04 |
| 13 | Dodeca-1,6-dien-12-ol, 6,10-dime | 27.466 | 0.69 |
| 14 | Linoleic acid | 27.670 | 2.87 |
| 15 | Propionic acid, 2-chloro-3-methoxy | 27.990 | 0.20 |

Chromatogram of the ethanolic extract of N. sativa.
GC-MS analysis confirmed the presence of many N. sativa seed extract compounds, including amino acids, proteins, carbohydrates, fixed oil, steroids, flavonoids, alkaloids, phenols, and quinones. The difference between the current study and others is the number of compounds detected in the extract; the present study discovered 15 compounds, another study discovered 23 [30], and 31 was found in ref. [35].
Many plant bioactive compounds are found and used to enhance good health and combat infection in humans and animals, and many of these compounds are sold as food or herbal medications [36,37]. Herbal medicine’s popularity among the general public has soared in recent years, in part due to the ease with which it can be obtained without a prescription, the low cost, and the ease of scheduling an appointment with a healthcare provider, but also because of the widespread belief that natural remedies are less dangerous than synthetic ones [38]. Many compounds in the N. sativa plant include volatile oils, cardiac glycosides, terpenoids, flavonoids, anthraquinones, sterols, alkaloids, saponins, and volatile bases [39].
3.2 Characterization
3.2.1 FESEM
The fabricated green-synthesized IONPs (Figure 2), with an average size of 31.45 nm, were visualized using the FESEM technique for displaying the size and shape of relatively spherical NPs.

FESEM micrographs of IONPs at different magnification; scales: (a) 1 µm, (b) 500 nm, (c) 200 nm, and (d) 100 nm.
3.2.2 XRD
The diffraction peak appeared at 2θ with 30.3°, 35.7°, 43.1°, 53.6°, 57.4°, and 62.6°, respectively, corresponding to the crystal structure of magnetite (220), (311), (400), (440), (531), and (533), indicating the formation of the anatase phase of green-synthesized IONPs (Figure 3). The peaks in Figure 3 show a broadening of the half maximum of the peak in green-synthesized IONPs and increased signal concerning the crystallographic plane 311. The XRD pattern of green-synthesized IONPs matched well with that of the standard reference for Fe3O4 (magnetite) from the database (JCPDS file no. 00-003-0863), and our results are also in good agreement with the previously reported studies [40].

XRD pattern of green-synthesized IONPs.
3.2.3 Dynamic light scattering (DLS) and zeta analysis
The DLS and ZP analysis of prepared green-synthesized IONPs are shown in Figures 4 and 5. The nature of hydrodynamic size (diameter) in DMSO of prepared green-synthesized IONPs was studied. DLS showed the hydrodynamic size distribution of small particles, and it refers to the size of the core and the materials used to cover it. For the green-synthesized IONP suspension in DMSO, a clear indicator for stability without particle settlement was found by the ZP analysis (Figure 5) (ζ = −51.8 mV), with an electrophoretic movement (mean) of −0.000402 cm2·V−1·s−1. The study on the prepared suspension also confirms the general ZP criteria negatively for improved stability [41,42].

DLS of the particle volume distribution size of green-synthesized IONPs using HORIBA Scientific Nanoparticle Analyzer SZ-100.

ZP analysis (ζ = −51.8 mV) of green-synthesized IONPs.
3.2.4 FTIR analysis
FTIR analysis was used to determine the functional groups of green-synthesized IONPs (Figure 6). Based on the peak value in the infrared radiation region, an FTIR spectroscope was used to determine the functional groups of active substances. The FTIR spectra of produced NPs ranged from 3,500 to 400 cm−1. The FTIR spectra of the produced IONPs were used to determine the groups responsible for NP capping and stabilization. Thirteen peaks were recorded including 3384.04, 2921.79, 2851.83, 2349.42, 1722.80, 1619.13, 1528.23, 1461.96, 1392.79, 1376.84, 1054.53, 582.29, and 443.39 cm−1. From these 13 peaks, about 4 peaks were extreme bands which are 3384.04 cm−1 (br), 1722.80 cm−1 (m), 1054.53 cm−1 (m), and 582.29 cm−1 (m), as shown in Figure 5 (m). These four bands have been linked to those found in Fe2O3 [43,44]. Peaks at 582.29 cm−1 (Fe–O) and 1722.80 cm−1 (H2O bending vibration), and a large peak at 3384.04 cm−1 are the vibration bands (H2O str). Instead of three distinct peaks, a broad peak of about 582.29 cm−1 (Fe–O str) was noticed, which could be due to an organic molecule from N. sativa extract on the surface of IONPs [40].

FTIR analysis of (a) green-synthesized IONPs and (b) standard IONPs.
3.3 MTT results
The MTT assay was used to evaluate the viability/proliferation of green-synthesized IONPs at various concentrations, 12.5, 25, 50, 100, and 200 μg·mL−1 for 48 h (Figure 7). Compared to the control group, the negative control and green-synthesized IONPs did not show any mentioned cytotoxicity at concentrations of 12.5, 25, 50, 100, and 200 μg·mL−1 for 48 h.

Cytotoxic effect of green-synthesized IONPs on Vero cells after exposure to different concentrations for 24 and 48 h compared to negative and positive control. Error bars represent mean ± SD; * mean highly significant difference p < 0.0001.
The current study agreed with that of Izadiyan et al., which approved no significant toxicity of green-synthesized IONPs (J. regia-IONPs) on normal cell lines at varying doses [42]. These findings show that these J. regia-IONPs can be used in various biomedical applications. Another study found the bio-functional starch/IONPs to have non-toxic effects on normal and malignant cervical cell lines, making them ideal candidates for various biological applications [45]. Khatami et al. fabricated super-paramagnetic IONPs (SPIONPs), utilizing a zero-calorie stevia extract as a reducing and stabilizing agent, and showed that the antioxidant activity of the generated NPs was found to be within acceptable limits [46,47,48]. These can be attributed to the presence of phytochemicals and bioactive substances such as flavonoids, quinones, tannins, and other compounds that play an essential role in the creation, capping, and stabilization of iron(ii) oxide NPs. These polyphenols and antioxidants protect the NPs from oxidation and aggregation and eventually inhibit the toxic effect of synthesized IONPs [49,50,51].
3.4 Antibacterial activity
Figure 8 shows that green-synthesized IONPs have more efficient antibacterial activity on S. aureus and E. coli. Green-synthesized IONPs exhibited attractive antimicrobial decrease by enhancing the specific surface area [52]. The disc diffusion test was used to determine the antibacterial impact of green-synthesized IONPs against E. coli and S. aureus (Figure 9), where an evident zone of growth inhibition of green-synthesized IONPs at a concentration of 0.1 mg·mL−1 was 12.34 ± 0.58 for E. coli and 11.52 ± 0.58 for S. aureus, respectively.

Inhibitory effects of the green-synthesized IONPs, IONPs, N. sativa extract, and erythromycin (C+ve) against pathogenic bacteria (E. coli and S. aureus) using disc diffusion assay. The results were compared with the DW as a negative control (C−ve). ** Highly significant differences p < 0.05; * significant differences p < 0.05.
Disc diffusion assay exhibiting the impact of green-synthesized NPs as antibacterial agents against S. aureus and E. coli. (1) Green synthesized (N. sativa-iron oxide) NPs, (2) IONPs, (3) N. sativa extract, (4) erythromycin (C +ve), and (5) DW (C −ve).
Antibacterial properties of green-synthesized IONPs were investigated against different pathogenic bacterial strains such as E. coli, S. aureus, B. subtilis, S. epidermidis, K. pneumoniae, and P. aeruginosa at various concentrations using the disc diffusion assay [53]. In general, all bacterial strains were susceptible to IONPs, except S. epidermidis and P. aeruginosa [54]. Similarly, antibacterial activity was observed for IONPs produced through the co-precipitation approach from Balanites aegyptiaca oil [55]. Khashan et al. used pulsed laser ablation in liquid for investigating the synthesis of IONPs at various concentrations doped with carbon nanotubes for antibacterial activity and wound dressing repair [56]. Medicinal plants with antibacterial activity have been employed infrequently in the production of IONPs. Our findings indicate that the green synthesis of the N. sativa-IONP compound possesses vigorous antibacterial activity against pathogenic bacterial strains (E. coli, S. aureus) [57].
Green-synthesized IONPs stuck in a suspension on bacterial surfaces, resulting in green-synthesized IONPs being adsorbed on the bacteria’s surface, which could be combined with a photocatalytic oxidation reaction to inactivate the bacteria [58]. Several possible mechanisms explain bacteria’s impact on green synthesis IONPs [59]. Scientific evidence shows that the formation of hydroxyl radicals, superoxide radicals, singlet oxygen, and hydrogen peroxide, collectively known as reactive oxygen species, can damage bacteria’s proteins and DNA, resulting in bactericidal action on IONPs [60].
4 Conclusion
In this work, we used the seed extract of N. sativa to synthesize IONPs in a green and environmentally friendly method. Chemically, the N. sativa seeds are highly diverse, and the GC-MS analysis revealed 15 substances in the plant extract. The synthesized NPs are 31.45 nm, stable and well distributed, and noncytotoxic to Vero cell lines. They have good antimicrobial activity against pathogenic E. coli and S. aureus bacterial strains.
Acknowledgements
The authors thank College of Veterinary Medicine, University of Al-Qadisiyah, Al-Diwaniyah, Iraq; Department of Basic Science, College of Science, University of Misan, Mayasn, Iraq; and Taif University for their technical support.
-
Funding information: Financial support was provided by the Taif University, Researchers Supporting Project number TURSP-2020/274.
-
Author contributions: Conceptualization and methodology: Hassan Al-Karagoly, Salim Albukhaty, Amal A. Alyamani, and Salman Aloufi; formal analysis: Hassan Al-Karagoly, Salim Albukhaty, Atiaf Rhyaf, Hala Naji, and Faiza Almaliki; investigation and data curation: Salim Albukhaty, Hala Naji, and Faiza Almaliki; validation: Hassan Al-Karagoly, Salim Albukhaty, Jawaher Albaqami, and Salman Aloufi; visualization: Amal A. Alyamani, Atife Rhyaf, and Jawaher Albaqami; writing – original draft preparation: Hassan Al-Karagoly, Salim Albukhaty, Atiaf Rhyaf, Hala Naji, Faiza Almaliki, Jawaher Albaqami, and Salman Aloufi; writing – review and editing: Hassan Al-Karagoly, Salim Albukhaty, Atiaf Rhyaf, Hala Naji, Faiza Almaliki, Jawaher Albaqami, and Salman Aloufi; supervision: Hassan Al-Karagoly; project administration: Hassan Al-Karagoly; funding acquisition: Faiza Almaliki, Jawaher Albaqami, Amal A. Alyamani, and Salman Aloufi. All authors approved the final version of the manuscript.
-
Conflict of interest: Authors state no conflict of interest.
References
[1] Kango S, Kalia S, Celli A, Njuguna J, Habibi Y, Kumar R. Surface modification of inorganic nanoparticles for development of organic–inorganic nanocomposites – a review. Prog Polym Sci. 2003;38(8):1232–61. 10.1016/j.progpolymsci.2013.02.003.Search in Google Scholar
[2] Sajid M, Płotka-Wasylka J. Nanoparticles: synthesis, characteristics, and applications in analytical and other sciences. Microchem J. 2020;154:104623. 10.1016/j.microc.2020.104623.Search in Google Scholar
[3] Kayani ZN, Arshad S, Riaz S, Naseem S. Synthesis of iron oxide nanoparticles by sol–gel technique and their characterization. EEE Trans Magn. 2014;50(8):1–4. 10.1109/TMAG.2014.2313763.Search in Google Scholar
[4] Albukhaty S, Al-Musawi S, Abdul Mahdi S, Sulaiman GM, Alwahibi MS, Dewir YH, et al. Investigation of dextran-coated superparamagnetic nanoparticles for targeted vinblastine controlled release, delivery, apoptosis induction, and gene expression in pancreatic cancer cells. Molecules. 2020;25(20):4721. 10.3390/molecules25204721.Search in Google Scholar PubMed PubMed Central
[5] Ge S, Shi X, Sun K, Li C, Uher C, Baker J, et al. Facile hydrothermal synthesis of iron oxide nanoparticles with tunable magnetic properties. J Phys Chem C. 2009;113(31):13593–9. 10.1021/jp902953t.Search in Google Scholar PubMed PubMed Central
[6] Ismail RA, Sulaiman GM, Abdulrahman SA. Preparation of iron oxide nanoparticles by laser ablation in DMF under effect of external magnetic field. Int J Mod Phys B. 2016;30(17):1650094. 10.1142/S0217979216500946.Search in Google Scholar
[7] Bhateria R, Singh R. A review on nanotechnological application of magnetic iron oxides for heavy metal removal. J Water Process Eng. 2019;31:100845. 10.1016/j.jwpe.2019.100845.Search in Google Scholar
[8] Alyamani AA, Albukhaty S, Aloufi S, AlMalki FA, Al-Karagoly H, Sulaiman GM. Green fabrication of zinc oxide nanoparticles using phlomis leaf extract: characterization and in vitro evaluation of cytotoxicity and antibacterial properties. Molecules. 2021;26(20):6140. 10.3390/molecules26206140.Search in Google Scholar PubMed PubMed Central
[9] El Shafey AM. Green synthesis of metal and metal oxide nanoparticles from plant leaf extracts and their applications: a review. Green Process Synth. 2020;9(1):304–39. 10.1515/gps-2020-0031.Search in Google Scholar
[10] Widdatallah MO, Mohamed AA, Alrasheid AA, Widatallah HA, Yassin LF, Eltilib SH, et al. Green synthesis of silver nanoparticles using nigella sativa seeds and evaluation of their antibacterial activity. ANP. 2020;9(2):41–8. 10.4236/anp.2020.92003.Search in Google Scholar
[11] Sreelakshmy V, Deepa MK, Mridula P. Green synthesis of silver nanoparticles from Glycyrrhiza glabra root extract for the treatment of gastric ulcer. J Develop Drugs. 2016;5(152):2.Search in Google Scholar
[12] Babu RH, Yugandhar P, Savithramma N. Synthesis, characterization and antimicrobial studies of bio silica nanoparticles prepared from Cynodon dactylon L.: a green approach. Bull Mater Sci. 2018;41(3):1–8. 10.1007/s12034-018-1584-4.Search in Google Scholar
[13] Chakravarty I, Pradeepam R, Kundu K, Singh P, Kundu S. Mycofabrication of gold nanoparticles and evaluation of their antioxidant activities. Curr Pharm Biotechnol. 2015;16(8):747–55. 10.2174/138920101608150603160620.Search in Google Scholar PubMed
[14] Vigneshwaran N, Ashtaputre NM, Varadarajan PV, Nachane RP, Paralikar KM, Balasubramanya RH. Biological synthesis of silver nanoparticles using the fungus Aspergillus flavus. Mater Lett. 2007;61(6):1413–8. 10.1016/j.matlet.2006.07.042.Search in Google Scholar
[15] Shende S, Gade A, Rai M. Large-scale synthesis and antibacterial activity of fungal-derived silver nanoparticles. Environ Chem Lett. 2017;15(3):427–34. 10.1007/s10311-016-0599-6.Search in Google Scholar
[16] Das RK, Pachapur VL, Lonappan L, Naghdi M, Pulicharla R, Maiti S, et al. Biological synthesis of metallic nanoparticles: plants, animals and microbial aspects. Nanotechnol Environ Eng. 2017;2(1):1–21. 10.1007/s41204-017-0029-4.Search in Google Scholar
[17] Ahmed SF, Mofijur M, Rafa N, Chowdhury AT, Chowdhury S, Nahrin M. Green approaches in synthesising nanomaterials for environmental nanobioremediation: technological advancements, applications, benefits and challenges. Environ Res. 2022;204:111967. 10.1016/j.envres.2021.111967.Search in Google Scholar PubMed
[18] Demirer GS, Okur AC, Kizilel S. Synthesis and design of biologically inspired biocompatible iron oxide nanoparticles for biomedical applications. J Mater Chem B. 2015;3(40):7831–49. 10.1039/C5TB00931F.Search in Google Scholar
[19] Kurhade P, Kodape S, Choudhury R. Overview on green synthesis of metallic nanoparticles. Chem Zvesti. 2021;75(10):1–36. 10.1007/s11696-021-01693-w.Search in Google Scholar
[20] Ahmed S, Chaudhry SA, Ikram S. A review on biogenic synthesis of ZnO nanoparticles using plant extracts and microbes: a prospect towards green chemistry. J Photochem Photobiol B Biol. 2017;166:272–84. 10.1016/j.jphotobiol.2016.12.011.Search in Google Scholar PubMed
[21] Mao Y, Park TJ, Zhang F, Zhou H, Wong SS. Environmentally friendly methodologies of nanostructure synthesis. Small. 2007;3(7):1122–39. 10.1002/smll.200700048.Search in Google Scholar PubMed
[22] Demirezen DA, Yıldız YŞ, Yılmaz Ş, Yılmaz DD. Synthesis and characterization of iron oxide nanoparticles using Ficus carica (common fig) dried fruit extract. J Biosci Bioeng. 2019;127(2):241–5. 10.1016/j.jbiosc.2018.07.024.Search in Google Scholar PubMed
[23] Üstün E, Önbaş SC, Çelik SK, Ayvaz MÇ, Şahin N. Green synthesis of iron oxide nanoparticles by using Ficus carica leaf extract and its antioxidant activity. Biointerface Res Appl Chem. 2021;12:2108–16.10.33263/BRIAC122.21082116Search in Google Scholar
[24] Bhuiyan MSH, Miah MY, Paul SC, Aka TD, Saha O, Rahaman MM, et al. Green synthesis of iron oxide nanoparticle using Carica papaya leaf extract: application for photocatalytic degradation of remazol yellow RR dye and antibacterial activity. Heliyon. 2020;6(8):e04603. 10.1016/j.heliyon.2020.e04603.Search in Google Scholar PubMed PubMed Central
[25] Deshmukh AR, Gupta A, Kim BS. Ultrasound assisted green synthesis of silver and iron oxide nanoparticles using fenugreek seed extract and their enhanced antibacterial and antioxidant activities. BioMed Res Int. 2019:1–14. 10.1155/2019/1714358.Search in Google Scholar PubMed PubMed Central
[26] Al-Zubaidy AM, Ghafoor BS, Rasul AA. The performance of two species of black cumin (Nigella sativa L.) and (Nigella arvensis L.) under different sowing dates in spring and autumn at Hallabja Governorate/Iraqi Kurdistan region. Ibn Al-Haitham J Pure Appl Sci. 2020;33(3):1–10. 10.30526/33.3.2465.Search in Google Scholar
[27] Ramadan MF. Nutritional value, functional properties and nutraceutical applications of black cumin (Nigella sativa L.): an overview. Int J Food Sci Technol. 2007;42(10):1208–18. 10.1111/j.1365-2621.2006.01417.x.Search in Google Scholar
[28] Jalali M, Tehranipour M. Effect of alcoholic extract of Nigella sativa seed on alpha motor neurons density of spinal cord following sciatic nerve compression in rats. J Gorgan Univ Med Sci. 2014;15(4):29–34.Search in Google Scholar
[29] Bawani SS, Anandhi DU. GC-MS analysis of nigella sativa seed extract and its ameliorative effects on transgenic drosophila model of Parkinson disease. Int J Eng Technol. 2021;4:16–22.Search in Google Scholar
[30] Nazeer A, George N. GC-MS analysis of n-hexane extract of Nigella sativa (seeds). Saudi J Med Pharm Sci. 2017;3:868–72.Search in Google Scholar
[31] Jabeen NS, Jagapriya L, Balasubramanian S, Devi K, Jeevanandam J. Phytochemical analysis of nigella sativa L. seeds aqueous extract by gas chromatography-mass spectroscopy and Fourier-transform infrared. 1st edn. Apple Academic Press; 2018. p. 587–604. 10.1201/9780429426223-2.Search in Google Scholar
[32] Bibi I, Nazar N, Ata S, Sultan M, Ali A, Abbas A, et al. Green synthesis of iron oxide nanoparticles using pomegranate seeds extract and photocatalytic activity evaluation for the degradation of textile dye. J Mater Res Technol. 2019;8(6):6115–24. 10.1016/j.jmrt.2019.10.006.Search in Google Scholar
[33] Al-Alawy AF, Al-Abodi EE, Kadhim RM. Synthesis and characterization of magnetic iron oxide nanoparticles by co-precipitation method at different conditions. J Eng. 2018;24(10):60–72. 10.31026/j.eng.2018.10.05.Search in Google Scholar
[34] Hudzicki J. Kirby-Bauer disk diffusion susceptibility test protocol. ASM. 2009;15:55–63.Search in Google Scholar
[35] Gerige SJ, Gerige MKY, Rao M. GC-MS analysis of Nigella sativa seeds and antimicrobial activity of its volatile oil. Braz Arch Biol Technol. 2009;52(5):1189–92. 10.1590/S1516-89132009000500016.Search in Google Scholar
[36] Nile SH, Park SW. Edible berries: bioactive components and their effect on human health. Nutrition. 2014;30(2):134–44. 10.1016/j.nut.2013.04.007.Search in Google Scholar PubMed
[37] Rochfort S, Parker AJ, Dunshea FR. Plant bioactives for ruminant health and productivity. Phytochemistry. 2008;69(2):299–322. 10.1016/j.phytochem.2007.08.017.Search in Google Scholar PubMed
[38] Verma S, Singh S. Current and future status of herbal medicines. Vet World. 2008;1(11):347. 10.5455/vetworld.2008.347-350.Search in Google Scholar
[39] Dubey PN, Singh B, Mishra BK, Kant K, Solanki RK. Nigella (Nigella sativa): a high value seed spice with immense medicinal potential. Indian J Agric Sci. 2016;86(8):967–79.10.56093/ijas.v86i8.60500Search in Google Scholar
[40] Rahman SSU, Qureshi MT, Sultana K, Rehman W, Khan MY, Asif MH. Single step growth of iron oxide nanoparticles and their use as glucose biosensor. Results Phys. 2017;7:4451–6. 10.1016/j.rinp.2017.11.001.Search in Google Scholar
[41] Şen M, Erboz EN. Determination of critical gelation conditions of κ-carrageenan by viscosimetric and FT-IR analyses. Food Res Int. 2010;43(5):1361–4. 10.1016/j.foodres.2010.03.021.Search in Google Scholar
[42] Izadiyan Z, Shameli K, Miyake M, Hara H, Mohamad SEB, Kalantari K, et al. Cytotoxicity assay of plant-mediated synthesized iron oxide nanoparticles using Juglans regia green husk extract. Arab J Chem. 2020;13(1):2011–23. 10.1016/j.arabjc.2018.02.019.Search in Google Scholar
[43] Kumar A, Singhal A. Synthesis of colloidal silver iron oxide nanoparticles – study of their optical and magnetic behavior. Nanotechnology. 2009;20(29):295606. 10.1088/0957-4484/20/29/295606.Search in Google Scholar PubMed
[44] Song HT, Choi JS, Huh YM, Kim S, Jun YW, Suh JS, et al. Surface modulation of magnetic nanocrystals in the development of highly efficient magnetic resonance probes for intracellular labeling. J Am Chem Soc. 2005;127(28):9992–3. 10.1021/ja051833y.Search in Google Scholar PubMed
[45] Gholoobi A, Meshkat Z, Abnous K, Ghayour-Mobarhan M, Ramezani M, Shandiz FH, et al. Biopolymer-mediated synthesis of Fe3O4 nanoparticles and investigation of their in vitro cytotoxicity effects. J Mol Struct. 2017;1141:594–9. 10.1016/j.molstruc.2017.04.024.Search in Google Scholar
[46] Khatami M, Alijani HQ, Fakheri B, Mobasseri MM, Heydarpour M, Farahani ZK, et al. Super-paramagnetic iron oxide nanoparticles (SPIONs): greener synthesis using Stevia plant and evaluation of its antioxidant properties. J Clean Prod. 2019;208:1171–7. 10.1016/j.jclepro.2018.10.182.Search in Google Scholar
[47] Al-Musawi S, Albukhaty S, Al-Karagoly H, Almalki F. Design and synthesis of multi-functional superparamagnetic core-gold shell nanoparticles coated with chitosan and folate for targeted antitumor therapy. Nanomaterials. 2021;11(1):32. 10.3390/nano11010032.Search in Google Scholar PubMed PubMed Central
[48] Albukhaty S, Naderi-Manesh H, Tiraihi T, Sakhi Jabir M. Poly-l-lysine-coated superparamagnetic nanoparticles: a novel method for the transfection of pro-BDNF into neural stem cells. Artificial Cells, Nanomed Biotechnol. 2018;46(sup3):S125–32. 10.1080/21691401.2018.1489272.Search in Google Scholar PubMed
[49] Nobahar A, Carlier JD, Miguel MG, Costa MC. A review of plant metabolites with metal interaction capacity: a green approach for industrial applications. BioMetals. 2021;34(4):1–33. 10.1007/s10534-021-00315-y.Search in Google Scholar PubMed
[50] Rehan M, Elshemy NS, Haggag K, Montaser AS, Ibrahim GE. Phytochemicals and volatile compounds of peanut red skin extract: simultaneous coloration and in situ synthesis of silver nanoparticles for multifunctional viscose fibers. Cellulose. 2020;27(17):9893–912. 10.1007/s10570-020-03452-8.Search in Google Scholar
[51] Chinnasamy G, Chandrasekharan S, Bhatnagar S. Biosynthesis of silver nanoparticles from Melia azedarach: enhancement of antibacterial, wound healing, antidiabetic and antioxidant activities. Int J Nanomedicine. 2019;14:9823. 10.2147/IJN.S231340.Search in Google Scholar PubMed PubMed Central
[52] Arias LS, Pessan JP, Vieira APM, Lima TMTD, Delbem ACB, Monteiro DR. Iron oxide nanoparticles for biomedical applications: a perspective on synthesis, drugs, antimicrobial activity, and toxicity. Antibiotics. 2018;7(2):46. 10.3390/antibiotics7020046.Search in Google Scholar PubMed PubMed Central
[53] Abo-zeid Y, Williams GR. The potential anti-infective applications of metal oxide nanoparticles: a systematic review. Wiley Interdisciplinary Rev Nanomed Nanobiotechnol. 2020;12(2):e1592. 10.1002/wnan.1592.Search in Google Scholar PubMed
[54] Sharma G, Dang S, Gupta S, Gabrani R. Antibacterial activity, cytotoxicity, and the mechanism of action of bacteriocin from Bacillus subtilis GAS101. Med Princ Pract. 2018;27(2):186–92. 10.1159/000487306.Search in Google Scholar PubMed PubMed Central
[55] Khalil AT, Ovais M, Ullah I, Ali M, Shinwari ZK, Maaza M. Biosynthesis of iron oxide (Fe2O3) nanoparticles via aqueous extracts of Sageretia thea (Osbeck.) and their pharmacognostic properties. Green Chem Lett Rev. 2017;10(4):186–201. 10.1080/17518253.2017.1339831.Search in Google Scholar
[56] Khashan KS, Sulaiman GM, Mahdi R. Preparation of iron oxide nanoparticles-decorated carbon nanotube using laser ablation in liquid and their antimicrobial activity. Artif Cells Nanomed Biotechnol. 2017;45(8):1699–709. 10.1080/21691401.2017.1282498.Search in Google Scholar PubMed
[57] Abid MA, Kadhim DA, Aziz WJ. Iron oxide nanoparticle synthesis using trigonella and tomato extracts and their antibacterial activity. Mater Technol. 2020;35:1–8. 10.1080/10667857.2020.1863572.Search in Google Scholar
[58] Ye Q, Chen W, Huang H, Tang Y, Wang W, Meng F. Iron and zinc ions, potent weapons against multidrug-resistant bacteria. Appl Microbiol Biotechnol. 2020;104(12):5213–27. 10.1007/s00253-020-10600-4.Search in Google Scholar PubMed
[59] Gudkov SV, Burmistrov DE, Serov DA, Rebezov MB, Semenova AA, Lisitsyn AB. Do iron oxide nanoparticles have significant antibacterial properties? Antibiotics. 2021;10(7):884. 10.3390/antibiotics10070884.Search in Google Scholar PubMed PubMed Central
[60] Das S, Diyali S, Vinothini G, Perumalsamy B, Balakrishnan G, Ramasamy T, et al. Synthesis, morphological analysis, antibacterial activity of iron oxide nanoparticles and the cytotoxic effect on lung cancer cell line. Heliyon. 2020;6(9):e04953. 10.1016/j.heliyon.2020.e04953.Search in Google Scholar PubMed PubMed Central
© 2022 Hassan Al-Karagoly et al., published by De Gruyter
This work is licensed under the Creative Commons Attribution 4.0 International License.
Articles in the same Issue
- Research Articles
- Kinetic study on the reaction between Incoloy 825 alloy and low-fluoride slag for electroslag remelting
- Black pepper (Piper nigrum) fruit-based gold nanoparticles (BP-AuNPs): Synthesis, characterization, biological activities, and catalytic applications – A green approach
- Protective role of foliar application of green-synthesized silver nanoparticles against wheat stripe rust disease caused by Puccinia striiformis
- Effects of nitrogen and phosphorus on Microcystis aeruginosa growth and microcystin production
- Efficient degradation of methyl orange and methylene blue in aqueous solution using a novel Fenton-like catalyst of CuCo-ZIFs
- Synthesis of biological base oils by a green process
- Efficient pilot-scale synthesis of the key cefonicid intermediate at room temperature
- Synthesis and characterization of noble metal/metal oxide nanoparticles and their potential antidiabetic effect on biochemical parameters and wound healing
- Regioselectivity in the reaction of 5-amino-3-anilino-1H-pyrazole-4-carbonitrile with cinnamonitriles and enaminones: Synthesis of functionally substituted pyrazolo[1,5-a]pyrimidine derivatives
- A numerical study on the in-nozzle cavitating flow and near-field atomization of cylindrical, V-type, and Y-type intersecting hole nozzles using the LES-VOF method
- Synthesis and characterization of Ce-doped TiO2 nanoparticles and their enhanced anticancer activity in Y79 retinoblastoma cancer cells
- Aspects of the physiochemical properties of SARS-CoV-2 to prevent S-protein receptor binding using Arabic gum
- Sonochemical synthesis of protein microcapsules loaded with traditional Chinese herb extracts
- MW-assisted hydrolysis of phosphinates in the presence of PTSA as the catalyst, and as a MW absorber
- Fabrication of silicotungstic acid immobilized on Ce-based MOF and embedded in Zr-based MOF matrix for green fatty acid esterification
- Superior photocatalytic degradation performance for gaseous toluene by 3D g-C3N4-reduced graphene oxide gels
- Catalytic performance of Na/Ca-based fluxes for coal char gasification
- Slow pyrolysis of waste navel orange peels with metal oxide catalysts to produce high-grade bio-oil
- Development and butyrylcholinesterase/monoamine oxidase inhibition potential of PVA-Berberis lycium nanofibers
- Influence of biosynthesized silver nanoparticles using red alga Corallina elongata on broiler chicks’ performance
- Green synthesis, characterization, cytotoxicity, and antimicrobial activity of iron oxide nanoparticles using Nigella sativa seed extract
- Vitamin supplements enhance Spirulina platensis biomass and phytochemical contents
- Malachite green dye removal using ceramsite-supported nanoscale zero-valent iron in a fixed-bed reactor
- Green synthesis of manganese-doped superparamagnetic iron oxide nanoparticles for the effective removal of Pb(ii) from aqueous solutions
- Desalination technology for energy-efficient and low-cost water production: A bibliometric analysis
- Biological fabrication of zinc oxide nanoparticles from Nepeta cataria potentially produces apoptosis through inhibition of proliferative markers in ovarian cancer
- Effect of stabilizers on Mn ZnSe quantum dots synthesized by using green method
- Calcium oxide addition and ultrasonic pretreatment-assisted hydrothermal carbonization of granatum for adsorption of lead
- Fe3O4@SiO2 nanoflakes synthesized using biogenic silica from Salacca zalacca leaf ash and the mechanistic insight into adsorption and photocatalytic wet peroxidation of dye
- Facile route of synthesis of silver nanoparticles templated bacterial cellulose, characterization, and its antibacterial application
- Synergistic in vitro anticancer actions of decorated selenium nanoparticles with fucoidan/Reishi extract against colorectal adenocarcinoma cells
- Preparation of the micro-size flake silver powders by using a micro-jet reactor
- Effect of direct coal liquefaction residue on the properties of fine blue-coke-based activated coke
- Integration of microwave co-torrefaction with helical lift for pellet fuel production
- Cytotoxicity of green-synthesized silver nanoparticles by Adansonia digitata fruit extract against HTC116 and SW480 human colon cancer cell lines
- Optimization of biochar preparation process and carbon sequestration effect of pruned wolfberry branches
- Anticancer potential of biogenic silver nanoparticles using the stem extract of Commiphora gileadensis against human colon cancer cells
- Fabrication and characterization of lysine hydrochloride Cu(ii) complexes and their potential for bombing bacterial resistance
- First report of biocellulose production by an indigenous yeast, Pichia kudriavzevii USM-YBP2
- Biosynthesis and characterization of silver nanoparticles prepared using seeds of Sisymbrium irio and evaluation of their antifungal and cytotoxic activities
- Synthesis, characterization, and photocatalysis of a rare-earth cerium/silver/zinc oxide inorganic nanocomposite
- Developing a plastic cycle toward circular economy practice
- Fabrication of CsPb1−xMnxBr3−2xCl2x (x = 0–0.5) quantum dots for near UV photodetector application
- Anti-colon cancer activities of green-synthesized Moringa oleifera–AgNPs against human colon cancer cells
- Phosphorus removal from aqueous solution by adsorption using wetland-based biochar: Batch experiment
- A low-cost and eco-friendly fabrication of an MCDI-utilized PVA/SSA/GA cation exchange membrane
- Synthesis, microstructure, and phase transition characteristics of Gd/Nd-doped nano VO2 powders
- Biomediated synthesis of ZnO quantum dots decorated attapulgite nanocomposites for improved antibacterial properties
- Preparation of metal–organic frameworks by microwave-assisted ball milling for the removal of CR from wastewater
- A green approach in the biological base oil process
- A cost-effective and eco-friendly biosorption technology for complete removal of nickel ions from an aqueous solution: Optimization of process variables
- Protective role of Spirulina platensis liquid extract against salinity stress effects on Triticum aestivum L.
- Comprehensive physical and chemical characterization highlights the uniqueness of enzymatic gelatin in terms of surface properties
- Effectiveness of different accelerated green synthesis methods in zinc oxide nanoparticles using red pepper extract: Synthesis and characterization
- Blueprinting morpho-anatomical episodes via green silver nanoparticles foliation
- A numerical study on the effects of bowl and nozzle geometry on performances of an engine fueled with diesel or bio-diesel fuels
- Liquid-phase hydrogenation of carbon tetrachloride catalyzed by three-dimensional graphene-supported palladium catalyst
- The catalytic performance of acid-modified Hβ molecular sieves for environmentally friendly acylation of 2-methylnaphthalene
- A study of the precipitation of cerium oxide synthesized from rare earth sources used as the catalyst for biodiesel production
- Larvicidal potential of Cipadessa baccifera leaf extract-synthesized zinc nanoparticles against three major mosquito vectors
- Fabrication of green nanoinsecticides from agri-waste of corn silk and its larvicidal and antibiofilm properties
- Palladium-mediated base-free and solvent-free synthesis of aromatic azo compounds from anilines catalyzed by copper acetate
- Study on the functionalization of activated carbon and the effect of binder toward capacitive deionization application
- Co-chlorination of low-density polyethylene in paraffin: An intensified green process alternative to conventional solvent-based chlorination
- Antioxidant and photocatalytic properties of zinc oxide nanoparticles phyto-fabricated using the aqueous leaf extract of Sida acuta
- Recovery of cobalt from spent lithium-ion battery cathode materials by using choline chloride-based deep eutectic solvent
- Synthesis of insoluble sulfur and development of green technology based on Aspen Plus simulation
- Photodegradation of methyl orange under solar irradiation on Fe-doped ZnO nanoparticles synthesized using wild olive leaf extract
- A facile and universal method to purify silica from natural sand
- Green synthesis of silver nanoparticles using Atalantia monophylla: A potential eco-friendly agent for controlling blood-sucking vectors
- Endophytic bacterial strain, Brevibacillus brevis-mediated green synthesis of copper oxide nanoparticles, characterization, antifungal, in vitro cytotoxicity, and larvicidal activity
- Off-gas detection and treatment for green air-plasma process
- Ultrasonic-assisted food grade nanoemulsion preparation from clove bud essential oil and evaluation of its antioxidant and antibacterial activity
- Construction of mercury ion fluorescence system in water samples and art materials and fluorescence detection method for rhodamine B derivatives
- Hydroxyapatite/TPU/PLA nanocomposites: Morphological, dynamic-mechanical, and thermal study
- Potential of anaerobic co-digestion of acidic fruit processing waste and waste-activated sludge for biogas production
- Synthesis and characterization of ZnO–TiO2–chitosan–escin metallic nanocomposites: Evaluation of their antimicrobial and anticancer activities
- Nitrogen removal characteristics of wet–dry alternative constructed wetlands
- Structural properties and reactivity variations of wheat straw char catalysts in volatile reforming
- Microfluidic plasma: Novel process intensification strategy
- Antibacterial and photocatalytic activity of visible-light-induced synthesized gold nanoparticles by using Lantana camara flower extract
- Antimicrobial edible materials via nano-modifications for food safety applications
- Biosynthesis of nano-curcumin/nano-selenium composite and their potentialities as bactericides against fish-borne pathogens
- Exploring the effect of silver nanoparticles on gene expression in colon cancer cell line HCT116
- Chemical synthesis, characterization, and dose optimization of chitosan-based nanoparticles of clodinofop propargyl and fenoxaprop-p-ethyl for management of Phalaris minor (little seed canary grass): First report
- Double [3 + 2] cycloadditions for diastereoselective synthesis of spirooxindole pyrrolizidines
- Green synthesis of silver nanoparticles and their antibacterial activities
- Review Articles
- A comprehensive review on green synthesis of titanium dioxide nanoparticles and their diverse biomedical applications
- Applications of polyaniline-impregnated silica gel-based nanocomposites in wastewater treatment as an efficient adsorbent of some important organic dyes
- Green synthesis of nano-propolis and nanoparticles (Se and Ag) from ethanolic extract of propolis, their biochemical characterization: A review
- Advances in novel activation methods to perform green organic synthesis using recyclable heteropolyacid catalysis
- Limitations of nanomaterials insights in green chemistry sustainable route: Review on novel applications
- Special Issue: Use of magnetic resonance in profiling bioactive metabolites and its applications (Guest Editors: Plalanoivel Velmurugan et al.)
- Stomach-affecting intestinal parasites as a precursor model of Pheretima posthuma treated with anthelmintic drug from Dodonaea viscosa Linn.
- Anti-asthmatic activity of Saudi herbal composites from plants Bacopa monnieri and Euphorbia hirta on Guinea pigs
- Embedding green synthesized zinc oxide nanoparticles in cotton fabrics and assessment of their antibacterial wound healing and cytotoxic properties: An eco-friendly approach
- Synthetic pathway of 2-fluoro-N,N-diphenylbenzamide with opto-electrical properties: NMR, FT-IR, UV-Vis spectroscopic, and DFT computational studies of the first-order nonlinear optical organic single crystal
Articles in the same Issue
- Research Articles
- Kinetic study on the reaction between Incoloy 825 alloy and low-fluoride slag for electroslag remelting
- Black pepper (Piper nigrum) fruit-based gold nanoparticles (BP-AuNPs): Synthesis, characterization, biological activities, and catalytic applications – A green approach
- Protective role of foliar application of green-synthesized silver nanoparticles against wheat stripe rust disease caused by Puccinia striiformis
- Effects of nitrogen and phosphorus on Microcystis aeruginosa growth and microcystin production
- Efficient degradation of methyl orange and methylene blue in aqueous solution using a novel Fenton-like catalyst of CuCo-ZIFs
- Synthesis of biological base oils by a green process
- Efficient pilot-scale synthesis of the key cefonicid intermediate at room temperature
- Synthesis and characterization of noble metal/metal oxide nanoparticles and their potential antidiabetic effect on biochemical parameters and wound healing
- Regioselectivity in the reaction of 5-amino-3-anilino-1H-pyrazole-4-carbonitrile with cinnamonitriles and enaminones: Synthesis of functionally substituted pyrazolo[1,5-a]pyrimidine derivatives
- A numerical study on the in-nozzle cavitating flow and near-field atomization of cylindrical, V-type, and Y-type intersecting hole nozzles using the LES-VOF method
- Synthesis and characterization of Ce-doped TiO2 nanoparticles and their enhanced anticancer activity in Y79 retinoblastoma cancer cells
- Aspects of the physiochemical properties of SARS-CoV-2 to prevent S-protein receptor binding using Arabic gum
- Sonochemical synthesis of protein microcapsules loaded with traditional Chinese herb extracts
- MW-assisted hydrolysis of phosphinates in the presence of PTSA as the catalyst, and as a MW absorber
- Fabrication of silicotungstic acid immobilized on Ce-based MOF and embedded in Zr-based MOF matrix for green fatty acid esterification
- Superior photocatalytic degradation performance for gaseous toluene by 3D g-C3N4-reduced graphene oxide gels
- Catalytic performance of Na/Ca-based fluxes for coal char gasification
- Slow pyrolysis of waste navel orange peels with metal oxide catalysts to produce high-grade bio-oil
- Development and butyrylcholinesterase/monoamine oxidase inhibition potential of PVA-Berberis lycium nanofibers
- Influence of biosynthesized silver nanoparticles using red alga Corallina elongata on broiler chicks’ performance
- Green synthesis, characterization, cytotoxicity, and antimicrobial activity of iron oxide nanoparticles using Nigella sativa seed extract
- Vitamin supplements enhance Spirulina platensis biomass and phytochemical contents
- Malachite green dye removal using ceramsite-supported nanoscale zero-valent iron in a fixed-bed reactor
- Green synthesis of manganese-doped superparamagnetic iron oxide nanoparticles for the effective removal of Pb(ii) from aqueous solutions
- Desalination technology for energy-efficient and low-cost water production: A bibliometric analysis
- Biological fabrication of zinc oxide nanoparticles from Nepeta cataria potentially produces apoptosis through inhibition of proliferative markers in ovarian cancer
- Effect of stabilizers on Mn ZnSe quantum dots synthesized by using green method
- Calcium oxide addition and ultrasonic pretreatment-assisted hydrothermal carbonization of granatum for adsorption of lead
- Fe3O4@SiO2 nanoflakes synthesized using biogenic silica from Salacca zalacca leaf ash and the mechanistic insight into adsorption and photocatalytic wet peroxidation of dye
- Facile route of synthesis of silver nanoparticles templated bacterial cellulose, characterization, and its antibacterial application
- Synergistic in vitro anticancer actions of decorated selenium nanoparticles with fucoidan/Reishi extract against colorectal adenocarcinoma cells
- Preparation of the micro-size flake silver powders by using a micro-jet reactor
- Effect of direct coal liquefaction residue on the properties of fine blue-coke-based activated coke
- Integration of microwave co-torrefaction with helical lift for pellet fuel production
- Cytotoxicity of green-synthesized silver nanoparticles by Adansonia digitata fruit extract against HTC116 and SW480 human colon cancer cell lines
- Optimization of biochar preparation process and carbon sequestration effect of pruned wolfberry branches
- Anticancer potential of biogenic silver nanoparticles using the stem extract of Commiphora gileadensis against human colon cancer cells
- Fabrication and characterization of lysine hydrochloride Cu(ii) complexes and their potential for bombing bacterial resistance
- First report of biocellulose production by an indigenous yeast, Pichia kudriavzevii USM-YBP2
- Biosynthesis and characterization of silver nanoparticles prepared using seeds of Sisymbrium irio and evaluation of their antifungal and cytotoxic activities
- Synthesis, characterization, and photocatalysis of a rare-earth cerium/silver/zinc oxide inorganic nanocomposite
- Developing a plastic cycle toward circular economy practice
- Fabrication of CsPb1−xMnxBr3−2xCl2x (x = 0–0.5) quantum dots for near UV photodetector application
- Anti-colon cancer activities of green-synthesized Moringa oleifera–AgNPs against human colon cancer cells
- Phosphorus removal from aqueous solution by adsorption using wetland-based biochar: Batch experiment
- A low-cost and eco-friendly fabrication of an MCDI-utilized PVA/SSA/GA cation exchange membrane
- Synthesis, microstructure, and phase transition characteristics of Gd/Nd-doped nano VO2 powders
- Biomediated synthesis of ZnO quantum dots decorated attapulgite nanocomposites for improved antibacterial properties
- Preparation of metal–organic frameworks by microwave-assisted ball milling for the removal of CR from wastewater
- A green approach in the biological base oil process
- A cost-effective and eco-friendly biosorption technology for complete removal of nickel ions from an aqueous solution: Optimization of process variables
- Protective role of Spirulina platensis liquid extract against salinity stress effects on Triticum aestivum L.
- Comprehensive physical and chemical characterization highlights the uniqueness of enzymatic gelatin in terms of surface properties
- Effectiveness of different accelerated green synthesis methods in zinc oxide nanoparticles using red pepper extract: Synthesis and characterization
- Blueprinting morpho-anatomical episodes via green silver nanoparticles foliation
- A numerical study on the effects of bowl and nozzle geometry on performances of an engine fueled with diesel or bio-diesel fuels
- Liquid-phase hydrogenation of carbon tetrachloride catalyzed by three-dimensional graphene-supported palladium catalyst
- The catalytic performance of acid-modified Hβ molecular sieves for environmentally friendly acylation of 2-methylnaphthalene
- A study of the precipitation of cerium oxide synthesized from rare earth sources used as the catalyst for biodiesel production
- Larvicidal potential of Cipadessa baccifera leaf extract-synthesized zinc nanoparticles against three major mosquito vectors
- Fabrication of green nanoinsecticides from agri-waste of corn silk and its larvicidal and antibiofilm properties
- Palladium-mediated base-free and solvent-free synthesis of aromatic azo compounds from anilines catalyzed by copper acetate
- Study on the functionalization of activated carbon and the effect of binder toward capacitive deionization application
- Co-chlorination of low-density polyethylene in paraffin: An intensified green process alternative to conventional solvent-based chlorination
- Antioxidant and photocatalytic properties of zinc oxide nanoparticles phyto-fabricated using the aqueous leaf extract of Sida acuta
- Recovery of cobalt from spent lithium-ion battery cathode materials by using choline chloride-based deep eutectic solvent
- Synthesis of insoluble sulfur and development of green technology based on Aspen Plus simulation
- Photodegradation of methyl orange under solar irradiation on Fe-doped ZnO nanoparticles synthesized using wild olive leaf extract
- A facile and universal method to purify silica from natural sand
- Green synthesis of silver nanoparticles using Atalantia monophylla: A potential eco-friendly agent for controlling blood-sucking vectors
- Endophytic bacterial strain, Brevibacillus brevis-mediated green synthesis of copper oxide nanoparticles, characterization, antifungal, in vitro cytotoxicity, and larvicidal activity
- Off-gas detection and treatment for green air-plasma process
- Ultrasonic-assisted food grade nanoemulsion preparation from clove bud essential oil and evaluation of its antioxidant and antibacterial activity
- Construction of mercury ion fluorescence system in water samples and art materials and fluorescence detection method for rhodamine B derivatives
- Hydroxyapatite/TPU/PLA nanocomposites: Morphological, dynamic-mechanical, and thermal study
- Potential of anaerobic co-digestion of acidic fruit processing waste and waste-activated sludge for biogas production
- Synthesis and characterization of ZnO–TiO2–chitosan–escin metallic nanocomposites: Evaluation of their antimicrobial and anticancer activities
- Nitrogen removal characteristics of wet–dry alternative constructed wetlands
- Structural properties and reactivity variations of wheat straw char catalysts in volatile reforming
- Microfluidic plasma: Novel process intensification strategy
- Antibacterial and photocatalytic activity of visible-light-induced synthesized gold nanoparticles by using Lantana camara flower extract
- Antimicrobial edible materials via nano-modifications for food safety applications
- Biosynthesis of nano-curcumin/nano-selenium composite and their potentialities as bactericides against fish-borne pathogens
- Exploring the effect of silver nanoparticles on gene expression in colon cancer cell line HCT116
- Chemical synthesis, characterization, and dose optimization of chitosan-based nanoparticles of clodinofop propargyl and fenoxaprop-p-ethyl for management of Phalaris minor (little seed canary grass): First report
- Double [3 + 2] cycloadditions for diastereoselective synthesis of spirooxindole pyrrolizidines
- Green synthesis of silver nanoparticles and their antibacterial activities
- Review Articles
- A comprehensive review on green synthesis of titanium dioxide nanoparticles and their diverse biomedical applications
- Applications of polyaniline-impregnated silica gel-based nanocomposites in wastewater treatment as an efficient adsorbent of some important organic dyes
- Green synthesis of nano-propolis and nanoparticles (Se and Ag) from ethanolic extract of propolis, their biochemical characterization: A review
- Advances in novel activation methods to perform green organic synthesis using recyclable heteropolyacid catalysis
- Limitations of nanomaterials insights in green chemistry sustainable route: Review on novel applications
- Special Issue: Use of magnetic resonance in profiling bioactive metabolites and its applications (Guest Editors: Plalanoivel Velmurugan et al.)
- Stomach-affecting intestinal parasites as a precursor model of Pheretima posthuma treated with anthelmintic drug from Dodonaea viscosa Linn.
- Anti-asthmatic activity of Saudi herbal composites from plants Bacopa monnieri and Euphorbia hirta on Guinea pigs
- Embedding green synthesized zinc oxide nanoparticles in cotton fabrics and assessment of their antibacterial wound healing and cytotoxic properties: An eco-friendly approach
- Synthetic pathway of 2-fluoro-N,N-diphenylbenzamide with opto-electrical properties: NMR, FT-IR, UV-Vis spectroscopic, and DFT computational studies of the first-order nonlinear optical organic single crystal